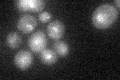
YBL014C
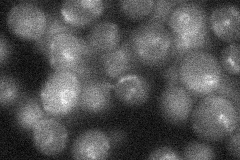
YBL014C
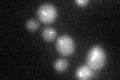
YBL014C

View description
Component of the core factor (CF) rDNA transcription factor complex; CF is required for transcription of 35S rRNA genes by RNA polymerase I and is composed of Rrn6p, Rrn7p, and Rrn11p
Localization:
Intensity:
Fold change:
Significance:
-
C’ GFP library in SD
nucleolus19.93 -
N' NOP1pr-GFP in SD

punctate,nucleus25.6381 -
N' TEF2pr-mCherry in SD

nucleus14.5107 -
N' NATIVEpr-GFP in SD
below threshold20.4215 -
N' TEF2pr-VC and Cyto-VN in SD

#N/A0 -
C’ GFP library in SD+DTT
nucleolus20.11No -
C’ GFP library in SD+H2O2

nucleolus17.740.89No -
C’ GFP library in Starvation Media

nucleolus17.880.89No -
C’ GFP library on the background of Pup2-DaMP

nucleolus -
C’ GFP library on the background of CCT mutant

nucleolus21.10851.05898No
